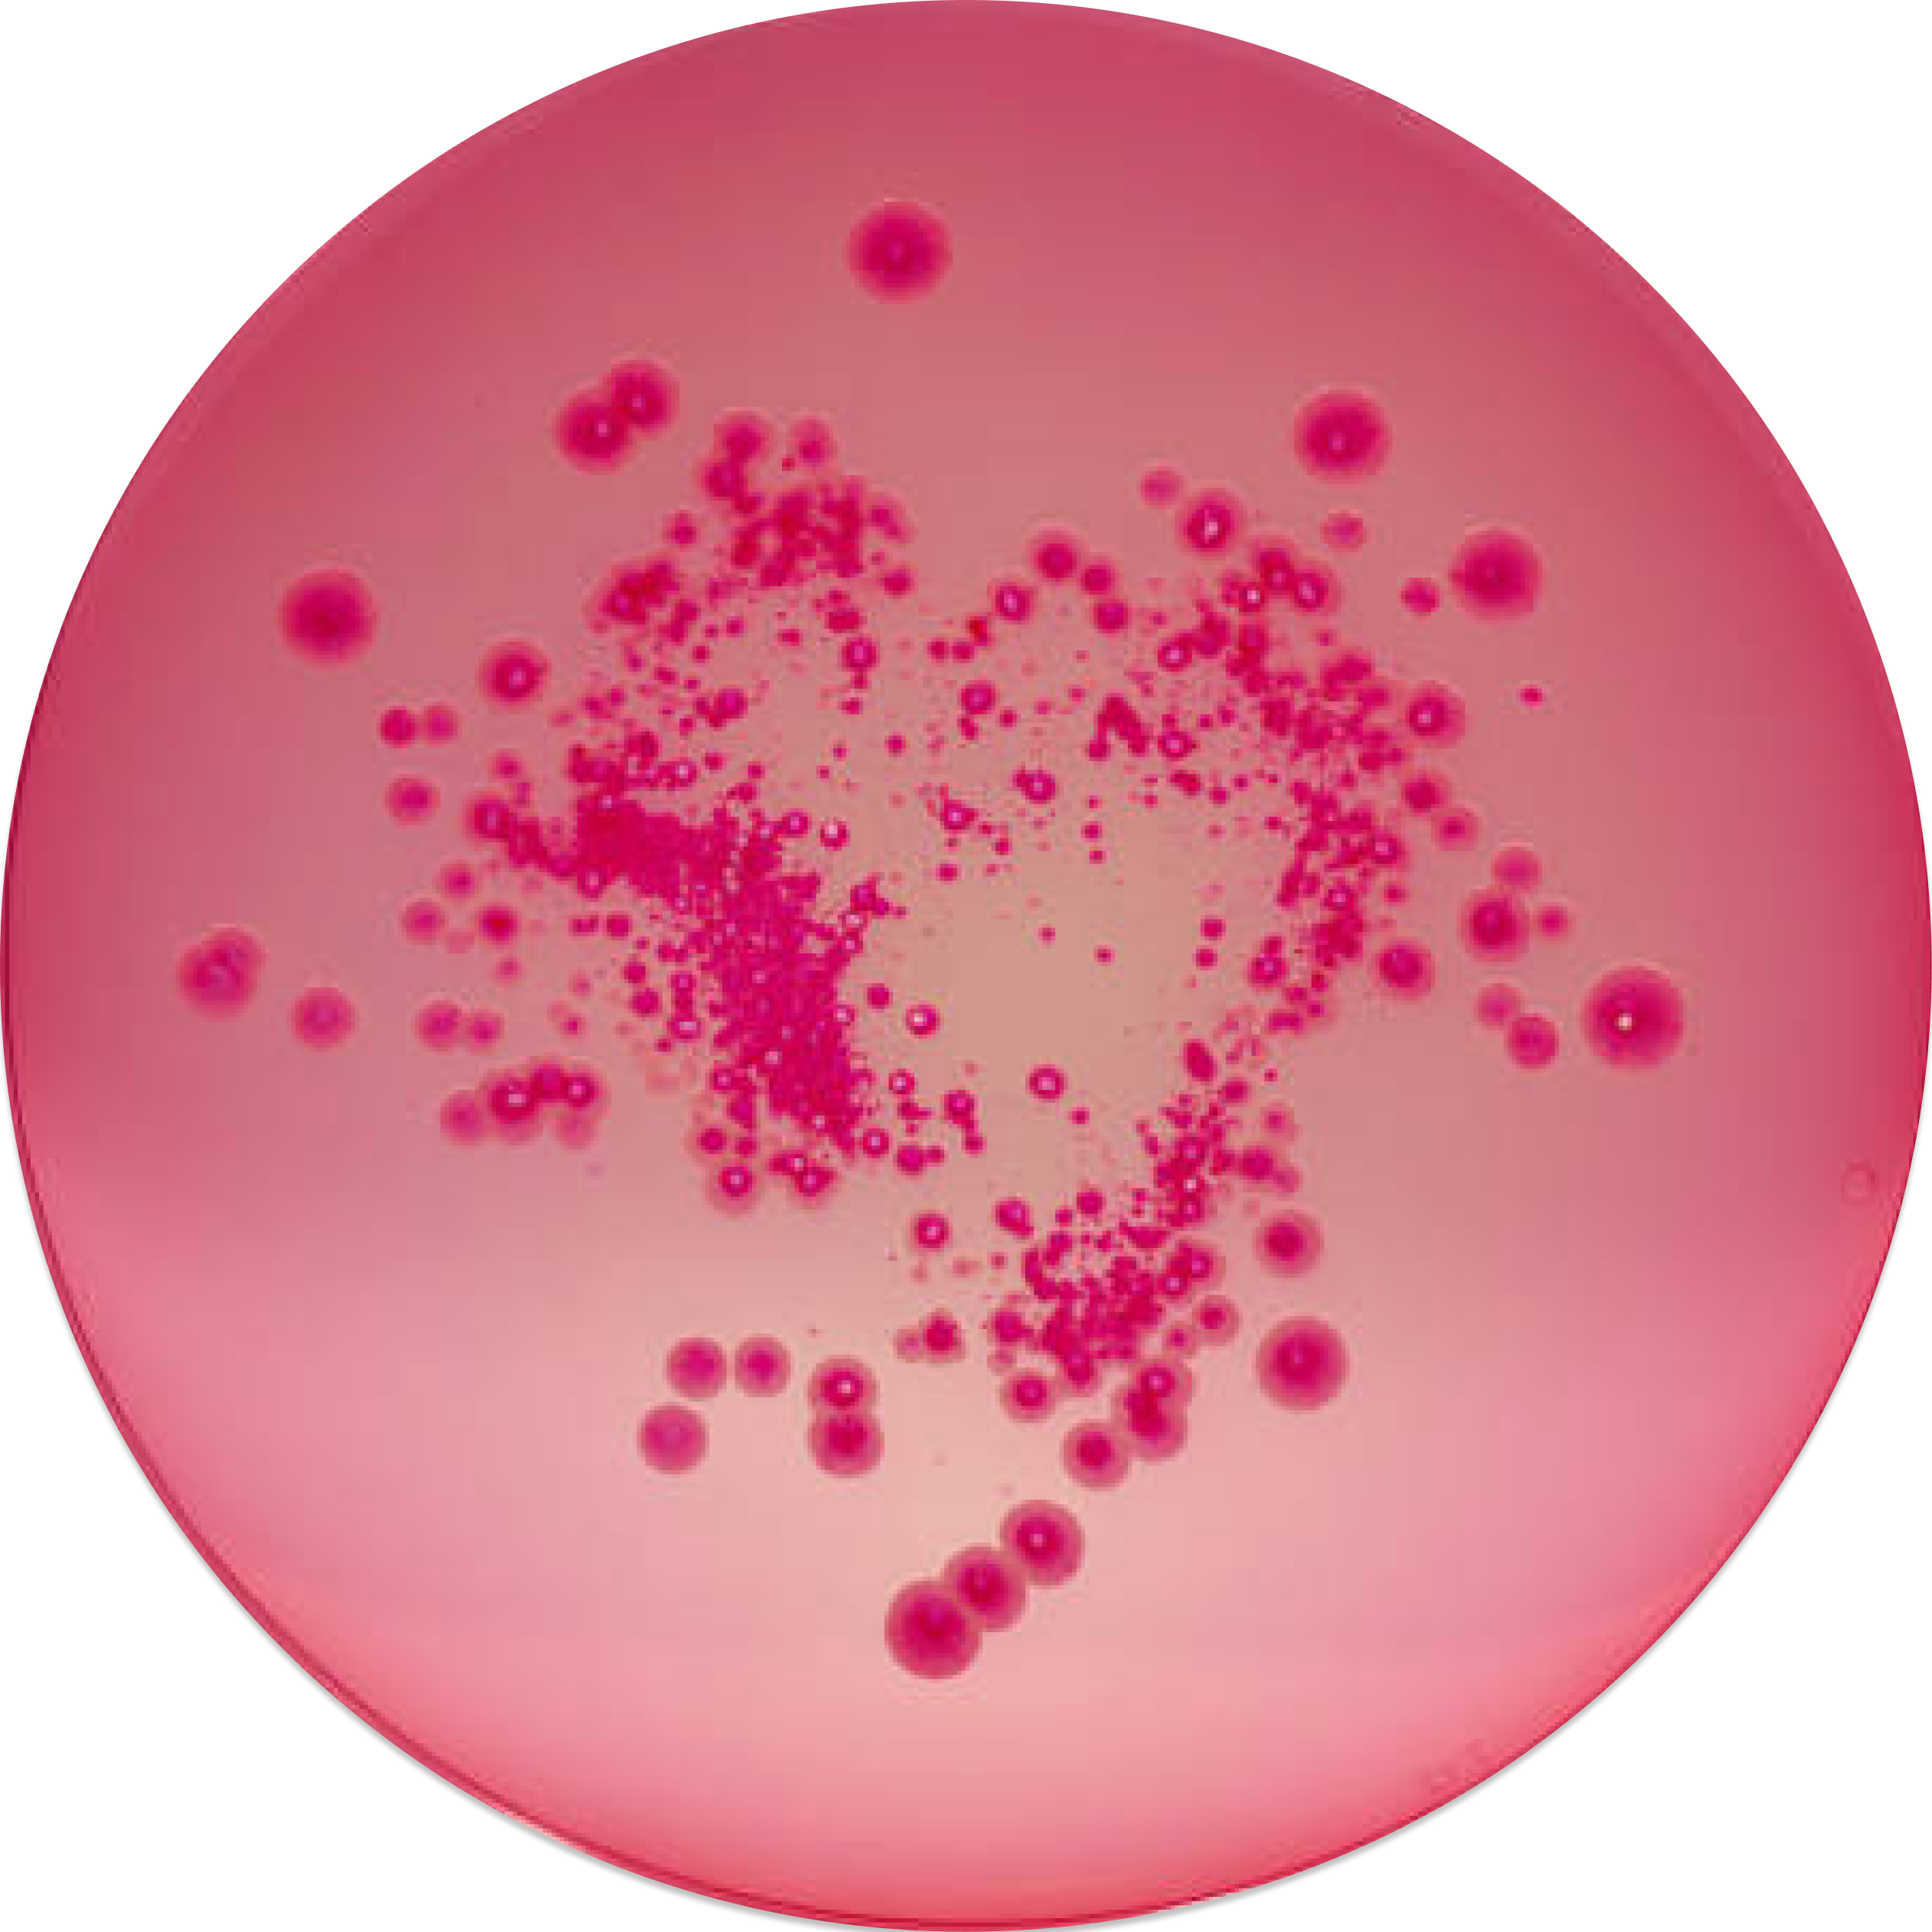

Petri - Music Platform
Web & App Design
2024
UX Designer · UI Designer

Year :
2024
Industry :
UX Design
Team Size :
5 Members
Project Duration :
12 weeks
Project info
Problem
Mainstream music platforms prioritize popular artists, making it difficult for local and emerging musicians to gain visibility. Listeners who want to discover local music often rely on fragmented tools like social media, flyers, or word of mouth, leading to disconnected experiences for both artists and fans.
Process
We conducted surveys and interviews to understand how people discover new music and how local artists promote their work. Our research focused on listening habits, discovery methods, and the importance of social features in music platforms.
Solution
Petri is a music streaming and community platform designed to highlight local artists and foster meaningful connections between musicians and listeners. The platform combines genre-based discovery, community discussion, and artist support tools into a single experience.
DISCOVERY
Helping users explore music beyond mainstream recommendations
COMMUNITY
Creating shared spaces for listeners and artists to connect
ARTIST SUPPORT
Giving artists visibility beyond streams and metrics

Age: 24
Location: Asheville, North Carolina
Bio: Marshall lives in Asheville, NC, a hub for local art and music. He enjoys discovering and supporting small artists, playing live shows, and releasing his own music, but feels major platforms don’t adequately represent independent creators.

Marshal
Music Enthusiast
Music Streamer
Small Musician
Community Supporter
Occupation: Small Musician and Waiter
Music enjoyer and player





RESEARCH & DISCOVERY
Understanding how people discover music and how artists reach listeners
We conducted surveys and interviews to explore how users currently discover new music and how local artists promote their work. Research focused on listening habits, discovery methods, and the importance of social features in music platforms.
“..most of the time I find new music through friends or social media.”
Designing systems that support both creators and listeners
This project reinforced the importance of research synthesis and designing community-focused systems that create value for both artists and audiences.
OUTCOME
KEY INSIGHTS
Music discovery is social, but existing platforms don’t support connection
Research revealed that users rely heavily on social and word-of-mouth discovery, while small artists struggle to gain meaningful visibility and engagement on major platforms. Streaming alone does not create community or lasting connection.
DESIGN DIRECTION
Shifting focus from algorithmic popularity to local connection
Based on these insights, we defined a design direction centered on local discovery, community interaction, and direct artist support. These principles guided feature prioritization and shaped the overall structure of the platform.
A community-first music experience built around discovery and interaction
Petri combines music streaming, genre-based discovery, and community discussion into a single experience designed to strengthen connections between listeners and local artists.
How current platforms approach music discovery and promotion
We reviewed existing music and social platforms to understand how they support discovery, artist visibility, and community interaction across different use cases.
COMPETITION
Apple Music
Spotify
Soundcloud
Soundcloud
Discord
VISUAL DIRECTION
Establishing a brand rooted in growth, texture, and community
The visual identity was inspired by organic growth and connection, reflecting how music evolves through shared experience and local communities.
The visual direction draws from how music grows and evolves through culture, similar to mold. The name Petri reflects something organic, interconnected, and full of potential, mirroring the diverse textures and styles found in music.
Petri
RESEARCH EVIDENCE
What listeners and artists told us
Survey results and interviews revealed that users rely heavily on social media and word-of-mouth for discovery, while artists struggle to gain visibility and sustained engagement on existing platforms.
IDEATION & EXPLORATION
Translating research into early concepts
Using insights around social discovery, community, and artist visibility, we explored multiple layout and feature concepts through low-fidelity sketches. These helped us rapidly test structure, hierarchy, and interaction patterns before committing to high-fidelity design.
STRUCTURE & FLOW
Defining core features through mid-fidelity wireframes
Building on the visual direction and research insights, we developed mid-fidelity wireframes to define core features, navigation flow, and information hierarchy. This phase focused on validating structure and interaction patterns before applying final visual styling.
Refining concepts through iteration and feedback
Based on early feedback and internal critique, we refined the strongest concepts and removed unnecessary complexity. This step helped clarify feature priorities and informed the final interaction and visual design.
USER PERSONA
Petri Music Screens
FINAL
DESIGN DECISIONS
DESIGN SOLUTION



